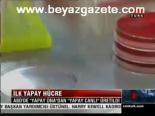
İlk Yapay Hücre

Video Arşivi
Ak Parti İl Başkanları Toplantısı
21 Mayıs 2010 Cuma 00:00:00Seçime Blok Liste İle Gidiliyor
CHP 33. Olağan Kurultayı yarın toplanıyor. Deniz Baykal'ın istifasıyla boşalan Genel Başkanlık için tek aday olan Kemal Kılıçdaroğlu ile gidilen kurul...
21 Mayıs 2010 Cuma 00:00:00Bakan Yıldız'ın Maden Değerlendirmesi
Zonguldak'ta meydana gelen maden patlamasında hayatını kaybeden 28 işçi son yolculuğuna uğurlandı. Yine acı yine gözyaşı vardı......
21 Mayıs 2010 Cuma 00:00:00Şehit Polisin Cenaze Töreni
Beşiktaş'taki Aşiyan Mezarlığı'nda çıkan çatışmada şehit olan polis memuru Turgay Yılmaz (22) için İstanbul Emniyet Müdürlüğü'nde tören düzenlendi....
21 Mayıs 2010 Cuma 00:00:00Chp'de Yaşananlar İbretle Haberiniyor
Başbakan Recep Tayyip Erdoğan, AK Parti 57. Genişletilmiş İl Başkanları toplantısında yaptığı konuşmada, Deniz Baykal'ın AK Parti'ye yönelik yaptığı s...
21 Mayıs 2010 Cuma 00:00:00Obama'nın Mektubuna Cevap
Başbakan Recep Tayyip Erdoğan, ABD Başkanı Obama'nın 20 Nisan 2010 tarihinde gönderdiği mektuba cevap verdi. ...
21 Mayıs 2010 Cuma 00:00:00Kobi'lere Destek Paketi
Sanayi ve Ticaret Bakanı Nihat Ergün, KOBİ'lere 6 farklı programda destek aktarılacak paketi açıklayarak, 263 milyon TL'lik paketle bu yıl 400 girişim...
21 Mayıs 2010 Cuma 00:00:00İşletmeler Desteklenecek
Sanayi ve Ticaret Bakanı Nihat Ergün, KOBİ'lere 6 farklı programda destek aktarılacak paketi açıklayarak, 263 milyon TL'lik paketle bu yıl 400 girişim...
21 Mayıs 2010 Cuma 00:00:00Kurultaya Saatler Kala
CHP 33. Olağan Kurultayı yarın toplanıyor. Deniz Baykal'ın istifasıyla boşalan Genel Başkanlık için tek aday olan Kemal Kılıçdaroğlu ile gidilen kurul...
21 Mayıs 2010 Cuma 00:00:00Zonguldak'ta Son Durum
21 Mayıs 2010 Cuma 00:00:00Zonguldak'ta Son Durum
TBMM Adalet Komisyonu Üyesi Avukat Yılmaz Tunç, Karadon'daki grizu faciasında ölen 30 madenciden 28'inin cesedine ulaşıldığını, 2 madencinin cesetleri...
21 Mayıs 2010 Cuma 00:00:00Türbede Ziyaretinde Hurafe
21 Mayıs 2010 Cuma 00:00:002 Bombacı Yakalandı
İstanbul Emniyet Müdürlüğü Terörle Mücadele Ekipleri, Yunanistan'daki kamplarda bomba eğitimi aldığı belirlenen 1 kadın, 1 erkek yasadışı örgüt üyesi ...
21 Mayıs 2010 Cuma 00:00:00Madenciler Ebediyete Uğurlandı
Zonguldak'ta meydana gelen maden patlamasında hayatını kaybeden 28 işçi son yolculuğuna uğurlandı. Yine acı yine gözyaşı vardı......
21 Mayıs 2010 Cuma 00:00:00Ekipler 2 İşçiyi Arıyor
TBMM Adalet Komisyonu Üyesi Avukat Yılmaz Tunç, Karadon'daki grizu faciasında ölen 30 madenciden 28'inin cesedine ulaşıldığını, 2 madencinin cesetleri...
21 Mayıs 2010 Cuma 00:00:00Onlar Çalışmak Zorunda
Zonguldak'ta meydana gelen maden patlamasında hayatını kaybeden 28 işçi son yolculuğuna uğurlandı. Yine acı yine gözyaşı vardı......
21 Mayıs 2010 Cuma 00:00:00Komplonun Adresini Gösterdi
Başbakan Recep Tayyip Erdoğan, AK Parti 57. Genişletilmiş İl Başkanları toplantısında yaptığı konuşmada, Deniz Baykal'ın AK Parti'ye yönelik yaptığı s...
21 Mayıs 2010 Cuma 00:00:00Chp'de Kurultaya Doğru
CHP 33. Olağan Kurultayı yarın toplanıyor. Deniz Baykal'ın istifasıyla boşalan Genel Başkanlık için tek aday olan Kemal Kılıçdaroğlu ile gidilen kurul...
21 Mayıs 2010 Cuma 00:00:00Uluslararası Bir Operasyon
21 Mayıs 2010 Cuma 00:00:00Çiçeği Burnunda Şehit Oldu
Beşiktaş'taki Aşiyan Mezarlığı'nda çıkan çatışmada şehit olan polis memuru Turgay Yılmaz (22) için İstanbul Emniyet Müdürlüğü'nde tören düzenlendi....
21 Mayıs 2010 Cuma 00:00:00Mezarlıkta Tedbirler Artırılmalı
Beşiktaş'taki Aşiyan Mezarlığı'nda çıkan çatışmada şehit olan polis memuru Turgay Yılmaz (22) için İstanbul Emniyet Müdürlüğü'nde tören düzenlendi....
21 Mayıs 2010 Cuma 00:00:00Hukuka Açık Müdahele
21 Mayıs 2010 Cuma 00:00:00Madencilere Son Veda
Zonguldak'ta meydana gelen maden patlamasında hayatını kaybeden 28 işçi son yolculuğuna uğurlandı. Yine acı yine gözyaşı vardı......
21 Mayıs 2010 Cuma 00:00:00Erdoğan: Bu Mesleğinde Kaderinde Var
Başbakan Recep Tayyip Erdoğan, AK Parti 57. Genişletilmiş İl Başkanları toplantısında yaptığı konuşmada, Deniz Baykal'ın AK Parti'ye yönelik yaptığı s...
21 Mayıs 2010 Cuma 00:00:00Hukukçular Tepkili
21 Mayıs 2010 Cuma 00:00:00Hamdi Yaver Aktan Kim?
21 Mayıs 2010 Cuma 00:00:00Tutukluluğa İtiraz
21 Mayıs 2010 Cuma 00:00:00Karanlık Kurul İşbaşında
21 Mayıs 2010 Cuma 00:00:00Et Fiyatları Ne Zaman Düşecek?
21 Mayıs 2010 Cuma 00:00:00Yankesiciler Yakalandı
21 Mayıs 2010 Cuma 00:00:00Beyaz Zehirin Pençesinde
21 Mayıs 2010 Cuma 00:00:00Eğitim Uçağı Düştü
Mersin'in Tarsus ilçesine bağlı Avadan köyünde özel bir uçuş okuluna ait eğitim uçağının düşmesi sonucu 2 kişi hayatını kaybetti. ...
21 Mayıs 2010 Cuma 00:00:00Tarih Yeniden Canlandı
Vakıflar Genel Müdürlüğü tarafından restorasyonu yapılan Ertuğrul Tekke Camii'nin açılışı, Cumhurbaşkanı Abdullah Gül'ün de hazır bulunduğu törenle ge...
21 Mayıs 2010 Cuma 00:00:008. Uluslararası Türkçe Olimpiyatları
Türkçe Öğretimi Derneği (TÜRKÇEDER) tarafından bu yıl 8. düzenlenen Uluslararası Türkçe Olimpiyatları, 120 ülkeden 750 öğrenciyi buluşturacak....
21 Mayıs 2010 Cuma 00:00:00Bebek Firarda
Geçtiğimiz yıl ABD'nin Teksas eyaletine bağlı San Antonio kentinde Mike Hubbard adlı otobüs şoförünün yolun ortasında duran bebeği son anda fark edere...
21 Mayıs 2010 Cuma 00:00:00Kobi'lere Destek Kredisi
Sanayi ve Ticaret Bakanı Nihat Ergün, KOBİ'lere 6 farklı programda destek aktarılacak paketi açıklayarak, 263 milyon TL'lik paketle bu yıl 400 girişim...
21 Mayıs 2010 Cuma 00:00:00Türkiye Brıc Ülkelerine Eklendi
21 Mayıs 2010 Cuma 00:00:00İki İşçi Halen Göçük Altında
TBMM Adalet Komisyonu Üyesi Avukat Yılmaz Tunç, Karadon'daki grizu faciasında ölen 30 madenciden 28'inin cesedine ulaşıldığını, 2 madencinin cesetleri...
21 Mayıs 2010 Cuma 00:00:00O Ocağa En Son İha İnmişti
Zonguldak'ta patlamanın meydana geldiği maden ocağının görüntüleri Ramazan ayında İHA objektiflerine yansımıştı....
21 Mayıs 2010 Cuma 00:00:005 Askeri Şehit Eden Teröristlere Karşı Operasyon
Beşiktaş'taki Aşiyan Mezarlığı'nda çıkan çatışmada şehit olan polis memuru Turgay Yılmaz (22) için İstanbul Emniyet Müdürlüğü'nde tören düzenlendi....
21 Mayıs 2010 Cuma 00:00:00Irak'ın Kuzeyindeki Terörist Unsurlara Harekat
Sarıyayla Karakolu'na saldırarak 5 askeri şehit eden teröristlerin izine Pülümür-Bingöl sınırında rastlandı....
21 Mayıs 2010 Cuma 00:00:00Tarsus'ta Eğitim Uçağı Düştü: 2 Ölü
Mersin'in Tarsus ilçesine bağlı Avadan köyünde özel bir uçuş okuluna ait eğitim uçağının düşmesi sonucu 2 kişi hayatını kaybetti. ...
21 Mayıs 2010 Cuma 00:00:00Şehit Polis İçin Tören
Beşiktaş'taki Aşiyan Mezarlığı'nda çıkan çatışmada şehit olan polis memuru Turgay Yılmaz (22) için İstanbul Emniyet Müdürlüğü'nde tören düzenlendi....
21 Mayıs 2010 Cuma 00:00:00Başbakan'dan Baykal'a Brütüslere Bak
Başbakan Recep Tayyip Erdoğan, AK Parti 57. Genişletilmiş İl Başkanları toplantısında yaptığı konuşmada, Deniz Baykal'ın AK Parti'ye yönelik yaptığı s...
21 Mayıs 2010 Cuma 00:00:00Chp 33. Kurultayına Hazırlanıyor
CHP 33. Olağan Kurultayı yarın toplanıyor. Deniz Baykal'ın istifasıyla boşalan Genel Başkanlık için tek aday olan Kemal Kılıçdaroğlu ile gidilen kurul...
21 Mayıs 2010 Cuma 00:00:00Kurultaya Blok Liste İle Gidilecek
CHP 33. Olağan Kurultayı yarın toplanıyor. Deniz Baykal'ın istifasıyla boşalan Genel Başkanlık için tek aday olan Kemal Kılıçdaroğlu ile gidilen kurul...
21 Mayıs 2010 Cuma 00:00:00Bebek Firarda
Geçtiğimiz yıl ABD'nin Teksas eyaletine bağlı San Antonio kentinde Mike Hubbard adlı otobüs şoförünün yolun ortasında duran bebeği son anda fark edere...
21 Mayıs 2010 Cuma 00:00:00Yankesiciler İşte Böyle Çalışıyor
21 Mayıs 2010 Cuma 00:00:00Erdoğan, Obama'nın Mektubuna Cevap Verdi
Başbakan Recep Tayyip Erdoğan, ABD Başkanı Obama'nın 20 Nisan 2010 tarihinde gönderdiği mektuba cevap verdi. ...
21 Mayıs 2010 Cuma 00:00:00Okullarda Serbest Kıyafet Uygulaması
21 Mayıs 2010 Cuma 00:00:00Kreşte Başına Dolap Kapağı Düştü
21 Mayıs 2010 Cuma 00:00:00Deprem Sonrasına Hazırlık Semineri
21 Mayıs 2010 Cuma 00:00:00Yaylaya Çıkmadan İneklerini Yıkadılar
21 Mayıs 2010 Cuma 00:00:00Babası İçin Ağladı
21 Mayıs 2010 Cuma 00:00:00Babası İçin Ağladı
Zonguldak'ta meydana gelen maden patlamasında hayatını kaybeden 28 işçi son yolculuğuna uğurlandı. Yine acı yine gözyaşı vardı......
21 Mayıs 2010 Cuma 00:00:00Şehit Polise Veda
Beşiktaş'taki Aşiyan Mezarlığı'nda çıkan çatışmada şehit olan polis memuru Turgay Yılmaz (22) için İstanbul Emniyet Müdürlüğü'nde tören düzenlendi. ...
21 Mayıs 2010 Cuma 00:00:00Kılıçdaroğlu Konuşmasını Hazırladı
CHP 33. Olağan Kurultayı yarın toplanıyor. Deniz Baykal'ın istifasıyla boşalan Genel Başkanlık için tek aday olan Kemal Kılıçdaroğlu ile gidilen kurul...
21 Mayıs 2010 Cuma 00:00:00Evinden Cephane Çıktı
Beşiktaş'taki Aşiyan Mezarlığı'nda çıkan çatışmada şehit olan polis memuru Turgay Yılmaz (22) için İstanbul Emniyet Müdürlüğü'nde tören düzenlendi....
21 Mayıs 2010 Cuma 00:00:00Yetkili Organlar Blok Listeyle Seçilecek
CHP 33. Olağan Kurultayı yarın toplanıyor. Deniz Baykal'ın istifasıyla boşalan Genel Başkanlık için tek aday olan Kemal Kılıçdaroğlu ile gidilen kurul...
21 Mayıs 2010 Cuma 00:00:00Kurultaya Geri Sayım
CHP 33. Olağan Kurultayı yarın toplanıyor. Deniz Baykal'ın istifasıyla boşalan Genel Başkanlık için tek aday olan Kemal Kılıçdaroğlu ile gidilen kurul...
21 Mayıs 2010 Cuma 00:00:00Kurultay'a Doğru
CHP 33. Olağan Kurultayı yarın toplanıyor. Deniz Baykal'ın istifasıyla boşalan Genel Başkanlık için tek aday olan Kemal Kılıçdaroğlu ile gidilen kurul...
21 Mayıs 2010 Cuma 00:00:00Asıl Yarış Listede
CHP 33. Olağan Kurultayı yarın toplanıyor. Deniz Baykal'ın istifasıyla boşalan Genel Başkanlık için tek aday olan Kemal Kılıçdaroğlu ile gidilen kurul...
21 Mayıs 2010 Cuma 00:00:00Artık Evi De Sakin
Deniz Baykal dönecek mi tartışmaları devam ederken Baykal CHP Genel Merkezi'ndeki odasını boşalttı....
21 Mayıs 2010 Cuma 00:00:00Baykal Devre Dışı Kaldı
CHP 33. Olağan Kurultayı yarın toplanıyor. Deniz Baykal'ın istifasıyla boşalan Genel Başkanlık için tek aday olan Kemal Kılıçdaroğlu ile gidilen kurul...
21 Mayıs 2010 Cuma 00:00:00Polemik Bu Kez Chp
Başbakan Recep Tayyip Erdoğan, AK Parti 57. Genişletilmiş İl Başkanları toplantısında yaptığı konuşmada, Deniz Baykal'ın AK Parti'ye yönelik yaptığı s...
21 Mayıs 2010 Cuma 00:00:00Komplonun Adresini Gösterdi
Başbakan Recep Tayyip Erdoğan, AK Parti 57. Genişletilmiş İl Başkanları toplantısında yaptığı konuşmada, Deniz Baykal'ın AK Parti'ye yönelik yaptığı s...
21 Mayıs 2010 Cuma 00:00:00Madencilerin Cenazeleri Defnedildi
Zonguldak'ta meydana gelen maden patlamasında hayatını kaybeden 28 işçi son yolculuğuna uğurlandı. Yine acı yine gözyaşı vardı......
21 Mayıs 2010 Cuma 00:00:00Uçağın Enkazı Bulundu
Afganistan'da pazartesi günü düşen Pamir Havayollarına ait uçağın enkaz bölgesine ulaşıldı. İHH İnsani Yardım Vakfı iki görevlisinin de olduğu uçaktan...
21 Mayıs 2010 Cuma 00:00:00Madencilere Veda
Zonguldak'ta meydana gelen maden patlamasında hayatını kaybeden 28 işçi son yolculuğuna uğurlandı. Yine acı yine gözyaşı vardı......
21 Mayıs 2010 Cuma 00:00:00Mersin'de Uçak Düştü
21 Mayıs 2010 Cuma 00:00:00Kana Bulayacaklardı
İstanbul Emniyet Müdürlüğü Terörle Mücadele Ekipleri, Yunanistan'daki kamplarda bomba eğitimi aldığı belirlenen 1 kadın, 1 erkek yasadışı örgüt üyesi ...
21 Mayıs 2010 Cuma 00:00:00Kobi'lere Cansuyu
Sanayi ve Ticaret Bakanı Nihat Ergün, KOBİ'lere 6 farklı programda destek aktarılacak paketi açıklayarak, 263 milyon TL'lik paketle bu yıl 400 girişim...
21 Mayıs 2010 Cuma 00:00:00Patlamaya Kader Yorumu
Başbakan Recep Tayyip Erdoğan, AK Parti 57. Genişletilmiş İl Başkanları toplantısında yaptığı konuşmada, Deniz Baykal'ın AK Parti'ye yönelik yaptığı s...
21 Mayıs 2010 Cuma 00:00:00Erdoğan Obama'ya Mektubunu İletti
Başbakan Recep Tayyip Erdoğan, ABD Başkanı Obama'nın 20 Nisan 2010 tarihinde gönderdiği mektuba cevap verdi. ...
21 Mayıs 2010 Cuma 00:00:00Türk Savaş Uçakları Pkk Hedeflerini Vurdu
Sarıyayla Karakolu'na saldırarak 5 askeri şehit eden teröristlerin izine Pülümür-Bingöl sınırında rastlandı....
21 Mayıs 2010 Cuma 00:00:00Faraç Ve Tan Chp'nin Teröre Bakışını Tartıştı
Sarıyayla Karakolu'na saldırarak 5 askeri şehit eden teröristlerin izine Pülümür-Bingöl sınırında rastlandı....
21 Mayıs 2010 Cuma 00:00:00Hırsızlık Anı Saniye Saniye Kaydedildi
21 Mayıs 2010 Cuma 00:00:00Limanları Açma Şartı
21 Mayıs 2010 Cuma 00:00:00İlk Yapay Hücre
Yapay DNA keşfinden sonra, laboratuvar ortamında kimyasal maddelerle üretilen bu DNA, hücre içine yerleştirildi ve hücre belirlenen genetik koda göre ...
21 Mayıs 2010 Cuma 00:00:00Gül İstanbul'da
Vakıflar Genel Müdürlüğü tarafından restorasyonu yapılan Ertuğrul Tekke Camii'nin açılışı, Cumhurbaşkanı Abdullah Gül'ün de hazır bulunduğu törenle ge...
21 Mayıs 2010 Cuma 00:00:00Türkçe Olimpiyatları
Türkçe Öğretimi Derneği (TÜRKÇEDER) tarafından bu yıl 8. düzenlenen Uluslararası Türkçe Olimpiyatları, 120 ülkeden 750 öğrenciyi buluşturacak....
21 Mayıs 2010 Cuma 00:00:00Oyuncu Turan Özdemir'e Motosiklet Çarptı
Muğla'nın Bodrum ilçesinde trafik kazası geçiren Dondurmam Gaymak filminin başrol oyuncusu Turan Özdemir yoğun bakıma alındı....
21 Mayıs 2010 Cuma 00:00:002 İşçiye Henüz Ulaşılamadı
TBMM Adalet Komisyonu Üyesi Avukat Yılmaz Tunç, Karadon'daki grizu faciasında ölen 30 madenciden 28'inin cesedine ulaşıldığını, 2 madencinin cesetleri...
21 Mayıs 2010 Cuma 00:00:00Aynı Asansörle İndiler...
Zonguldak'ta meydana gelen maden patlamasında hayatını kaybeden 28 işçi son yolculuğuna uğurlandı. Yine acı yine gözyaşı vardı......
21 Mayıs 2010 Cuma 00:00:00Ben Senin Memurun Muyum?
Başbakan Recep Tayyip Erdoğan, AK Parti 57. Genişletilmiş İl Başkanları toplantısında yaptığı konuşmada, Deniz Baykal'ın AK Parti'ye yönelik yaptığı s...
21 Mayıs 2010 Cuma 00:00:00Baykal Çankaya'ya Yakışır
CHP 33. Olağan Kurultayı yarın toplanıyor. Deniz Baykal'ın istifasıyla boşalan Genel Başkanlık için tek aday olan Kemal Kılıçdaroğlu ile gidilen kurul...
21 Mayıs 2010 Cuma 00:00:00Madencilere Acı Veda
Zonguldak'ta meydana gelen maden patlamasında hayatını kaybeden 28 işçi son yolculuğuna uğurlandı. Yine acı yine gözyaşı vardı......
21 Mayıs 2010 Cuma 00:00:00Baykal Odasını Boşalttı
Deniz Baykal dönecek mi tartışmaları devam ederken Baykal CHP Genel Merkezi'ndeki odasını boşalttı....
21 Mayıs 2010 Cuma 00:00:00Chp Kurultayı - Fehmi Koru Yorumluyor
CHP 33. Olağan Kurultayı yarın toplanıyor. Deniz Baykal'ın istifasıyla boşalan Genel Başkanlık için tek aday olan Kemal Kılıçdaroğlu ile gidilen kurul...
21 Mayıs 2010 Cuma 00:00:00Kurultay'a Saatler Kala...
CHP 33. Olağan Kurultayı yarın toplanıyor. Deniz Baykal'ın istifasıyla boşalan Genel Başkanlık için tek aday olan Kemal Kılıçdaroğlu ile gidilen kurul...
21 Mayıs 2010 Cuma 00:00:00Maden İşçileri Toprağa Verildi
Zonguldak'ta meydana gelen maden patlamasında hayatını kaybeden 28 işçi son yolculuğuna uğurlandı. Yine acı yine gözyaşı vardı......
21 Mayıs 2010 Cuma 00:00:00Atatürk - İnönü - Baykal
CHP 33. Olağan Kurultayı yarın toplanıyor. Deniz Baykal'ın istifasıyla boşalan Genel Başkanlık için tek aday olan Kemal Kılıçdaroğlu ile gidilen kurul...
21 Mayıs 2010 Cuma 00:00:00Hala İki İşçi Aranıyor
TBMM Adalet Komisyonu Üyesi Avukat Yılmaz Tunç, Karadon'daki grizu faciasında ölen 30 madenciden 28'inin cesedine ulaşıldığını, 2 madencinin cesetleri...
21 Mayıs 2010 Cuma 00:00:00Rahşan Ecevit: Haydi Chp'ye
Eski Başbakanlardan Bülent Ecevit'in eşi Rahşan Ecevit, daha önce birlikte çalıştığı siyasilere ve Ecevit'e gönül verenlere, 'Kemal Kılıçdaroğlu'na ve...
21 Mayıs 2010 Cuma 00:00:00Sıra Kerem Kılıçdaroğlu'nda
21 Mayıs 2010 Cuma 00:00:00Chp'de Kurultay Hazırlığı
CHP 33. Olağan Kurultayı yarın toplanıyor. Deniz Baykal'ın istifasıyla boşalan Genel Başkanlık için tek aday olan Kemal Kılıçdaroğlu ile gidilen kurul...
21 Mayıs 2010 Cuma 00:00:00Bir Grup Partili Baykal'ın Evinde
21 Mayıs 2010 Cuma 00:00:00Teröristler Öldürüldü
Sarıyayla Karakolu'na saldırarak 5 askeri şehit eden teröristlerin izine Pülümür-Bingöl sınırında rastlandı....
21 Mayıs 2010 Cuma 00:00:00İçlerindeki Brütüslere Baksınlar
Başbakan Recep Tayyip Erdoğan, AK Parti 57. Genişletilmiş İl Başkanları toplantısında yaptığı konuşmada, Deniz Baykal'ın AK Parti'ye yönelik yaptığı s...
21 Mayıs 2010 Cuma 00:00:002 Terörist Yakalandı
İstanbul Emniyet Müdürlüğü Terörle Mücadele Ekipleri, Yunanistan'daki kamplarda bomba eğitimi aldığı belirlenen 1 kadın, 1 erkek yasadışı örgüt üyesi ...
21 Mayıs 2010 Cuma 00:00:00